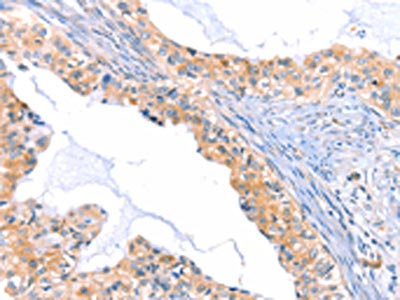

THBS1 Antibody
-
中文名稱(chēng):THBS1兔多克隆抗體
-
貨號(hào):CSB-PA901283
-
規(guī)格:¥1100
-
圖片:
-
The image on the left is immunohistochemistry of paraffin-embedded Human thyroid cancer tissue using CSB-PA901283(THBS1 Antibody) at dilution 1/60, on the right is treated with synthetic peptide. (Original magnification: ×200)
-
The image on the left is immunohistochemistry of paraffin-embedded Human cervical cancer tissue using CSB-PA901283(THBS1 Antibody) at dilution 1/60, on the right is treated with synthetic peptide. (Original magnification: ×200)
-
-
其他:
產(chǎn)品詳情
-
Uniprot No.:
-
基因名:
-
別名:THBS 1 antibody; THBS antibody; Thbs1 antibody; Thrombospondin 1 antibody; Thrombospondin-1 antibody; TSP 1 antibody; TSP antibody; TSP1 antibody; TSP1_HUMAN antibody
-
宿主:Rabbit
-
反應(yīng)種屬:Human,Mouse
-
免疫原:Synthetic peptide of Human THBS1
-
免疫原種屬:Homo sapiens (Human)
-
標(biāo)記方式:Non-conjugated
-
抗體亞型:IgG
-
純化方式:Antigen affinity purification
-
濃度:It differs from different batches. Please contact us to confirm it.
-
保存緩沖液:-20°C, pH7.4 PBS, 0.05% NaN3, 40% Glycerol
-
產(chǎn)品提供形式:Liquid
-
應(yīng)用范圍:ELISA,IHC
-
推薦稀釋比:
Application Recommended Dilution ELISA 1:1000-1:5000 IHC 1:50-1:200 -
Protocols:
-
儲(chǔ)存條件:Upon receipt, store at -20°C or -80°C. Avoid repeated freeze.
-
貨期:Basically, we can dispatch the products out in 1-3 working days after receiving your orders. Delivery time maybe differs from different purchasing way or location, please kindly consult your local distributors for specific delivery time.
-
用途:For Research Use Only. Not for use in diagnostic or therapeutic procedures.
相關(guān)產(chǎn)品
靶點(diǎn)詳情
-
功能:Adhesive glycoprotein that mediates cell-to-cell and cell-to-matrix interactions. Binds heparin. May play a role in dentinogenesis and/or maintenance of dentin and dental pulp. Ligand for CD36 mediating antiangiogenic properties. Plays a role in ER stress response, via its interaction with the activating transcription factor 6 alpha (ATF6) which produces adaptive ER stress response factors.
-
基因功能參考文獻(xiàn):
- High THBS1 expression is associated with migration, invasion, and progression of bladder cancer. PMID: 29602637
- intracellular dynamics of the TSP1-induced apoptosis signaling pathway PMID: 29258506
- TSP-1 effectively elevated P. gingivalis LPS-induced inflammation mediated by the NF-kappaB pathway and may be critical for pathology of periodontitis. PMID: 28634844
- These findings indicate that PRR13/THBS1 and TXN expression could be used for the prediction of resistance to treatment of epithelial ovarian cancer patients. PMID: 27779244
- TSP-1 appears to play an accessory role in modulating Mp activity in humans and BlaJ mice in a gender, age and muscle-dependent manner, but is unlikely a primary driver of disease progression of dysferlinopathy. PMID: 29206970
- TSP-4 A387P polymorphism, but not TSP-1 polymorphism, is an independent risk factor for acute myocardial infarction in Egyptians. PMID: 29336258
- Results show that the thrombospondin 1 (TSP1) and its receptor CD47 (CD47) axis selectively regulates NADPH oxidase 1 (Nox1) in the regulation of endothelial senescence and suggest potential targets for controlling the aging process at the molecular level. PMID: 29042481
- 15-LOX-1 expression in colon and prostate cancer cells leads to reduced angiogenesis. These changes could be mediated by an increase in the expression of both ICAM-1 and the anti-angiogenic protein TSP-1. PMID: 28757355
- miR-98 can suppress the expression of TSP1 in the peripheral B cells of patients with allergic asthma. PMID: 28760845
- Data indicate correlation between the levels of thrombospondin-1 and overall survival of ovarian cancer patients, suggesting thrombospondin-1 may be used as a prognostic factor in ovarian cancer patients. PMID: 28655131
- Studies show that thrombospondin-1 (Thbs-1), is a prolific contributor to the production and modulation of ROS in large conductance vessels and in the peripheral circulation. Recently, the presence of physiologically relevant circulating Thbs-1 levels was proven to also disrupt vasodilation to nitric oxide (NO) in coronary arterioles from aged animals, negatively impacting coronary blood flow reserve. [review] PMID: 28762749
- Our findings suggest that Rab37-mediated TSP1 secretion in cancer cells suppresses metastasis and angiogenesis via a cross-talk with endothelial cells and reveal a novel component of the vesicular exocytic machinery in tumor microenvironment and tumor progression PMID: 28151721
- TSP-1 strongly potentiated the proliferative and migratory activity of PDGF on mesenchymal stromal cells. PMID: 26992552
- This study demonstrated that THBS! was detected in the serums of Alzheimer disease patients. PMID: 27911324
- Functional studies showed THBS1 and TNC to mediate chemoresistance through the integrin beta1/mTOR pathway. PMID: 27487140
- These findings shed light on the mechanisms leading to beta-cell failure during metabolic stress and point to THBS1 as an interesting therapeutic target to prevent oxidative stress in type 2 diabetes. PMID: 27588705
- Thrombospondin-1 gene polymorphism is associated with estimated pulmonary artery pressure in patients with sickle cell anemia. PMID: 28033687
- High plasma levels of TSP-1 are associated with increased pulmonary arterial pressure, increased pulmonary vascular resistance and decreased survival pulmonary hypertension. PMID: 27473366
- Genetic variants of THBS1 were significantly more frequent in patients affected by idiopathic/genetic generalized epilepsies than in non-epileptic controls. PMID: 28913875
- In pulmonary hypertension TSP1-CD47 is upregulated, and contributes to pulmonary arterial vasculopathy and dysfunction. PMID: 27742621
- High THBS1 expression is associated with primary effusion lymphoma. PMID: 28146424
- KLK4 further liberated an N-terminal product, with purported angiogenic activity, from thrombospondin-1 (TSP1) and cleaved TSP1 in an osteoblast-derived matrix. PMID: 27378148
- Data suggest pituitary cells secrete factor (TSP1) that binds to and inhibits action of BMP2 and BMP4; von Willebrand type C domain of TSP1 is likely responsible for this BMP2/4-binding activity. These studies were initially conducted using cultured cells from ovine pituitary gland and mouse cell line; interactions were confirmed using recombinant human proteins. (TSP1 = thrombospondin-1; BMP = bone morphogenetic protein) PMID: 28747434
- the results obtained by combining bioinformatics and preclinical studies strongly suggest that targeting TSP-1/CD47 axis may represent a valuable therapeutic alternative for hampering melanoma spreading. PMID: 27349907
- The levels of CD36, STAT3 and TGFbetaR2 mRNA were significantly higher in the TSP1-high group. PMID: 28668845
- Study discovered novel and independent associations of prediabetes and related traits with MASP1, and some evidence for associations with THBS1, GPLD1 and ApoA-IV, suggesting a role for these proteins in the pathophysiology of type 2 diabetes. PMID: 27344311
- TSP-1 deficiency promotes maladaptive remodelling of the ECM leading to accelerated abdominal aortic aneurysms progression. PMID: 28364044
- Low THBS1 expression is associated with lung cancer. PMID: 27513329
- FGF7 stimulation of cell invasion and migration was partially suppressed by the FGFR2 knockdown. In addition, FGF7/FGFR2 upregulated THBS1, and cell invasion and migration were decreased by knockdown of THBS1 PMID: 28339036
- Introduces a computational model that describes the mechanistic interactions between intracellular biomolecules and cooperation between signaling pathways that together make up the complex network of TSP-1 regulation both at the transcriptional and post-transcriptional level. PMID: 28045898
- Peg3 Induces Thrombospondin 1 Secretion and Inhibits Capillary Morphogenesis Independently of Beclin 1. PMID: 28174297
- The simulated model of the fully calcium-loaded and calcium-depleted TSP1-Sig1 may enable the development of its interactions as a novel therapeutic target for the treatment of vascular diseases. PMID: 27485292
- Regulatory elements for both IRF-1 (-1019 to -1016) and CREB (-1198 to -1195), specific to the distal THBS1 promoter, were required for leptin-induced TSP-1 transcription. PMID: 27281481
- Competitive inhibition experiments with other pneumococcal hTSP-1 adhesins demonstrated that PspC and PspC-like Hic recognize similar domains, whereas PavB and Hic can bind simultaneously to hTSP-1. PMID: 28209711
- Methylation of DAPK and THBS1 genes occurs in esophageal gastric-type columnar metaplasia and is associated with H. pylori cagA positive infection. PMID: 27182166
- Within the limitations of this study, the results seem to sustain the involvement of Pentraxin 3 and Thrombospondin 1 in the processes of inflammation and angiogenesis in wound healing of patients with postorthodontic gingivectomy. PMID: 27403446
- Circulating TSP-1 levels decrease up to 24 months prior to diagnosis of PDAC and significantly enhance the diagnostic performance of CA19-9. The influence of diabetes mellitus on biomarker behavior should be considered in future studies. PMID: 26573598
- F-actin dynamics modulate the patterning of TSP1 in extracellular matrix and that TSP1 oligomer state is a key determinant of this process. PMID: 26182380
- TSP-1 regulates multiple microRNAs in VSMCs adding a new layer of complexity to TSP-1 regulation of VSMC function PMID: 26728995
- quercetin could increase TSP-1 expression to inhibit angiogenesis resulting in antagonizing prostate cancer PC-3 cell and xenograft tumor growth PMID: 26676551
- The anti-angiogenic activity of the native TSP-1 active fragment was maintained in the new TSP-1 mimetics and the results provide a new chemical approach for the design of TSP-1 mimetics. PMID: 26464514
- In the current study Factor V Leiden, prothrombin G20210A, and thrombospondin-1 polymorphisms showed no association with severity of hepatic fibrosis. PMID: 26768578
- Triptolide can down regulates the expression of thrombospondin 1 and TGF-beta-1 in renal tubular cells. This plays a role in the pathogenesis of renal tubular fibrosis. PMID: 25945607
- increased plasma thrombospondin-1 concentrations following ICH are independently associated with injury severity and short-term and long-term clinical outcomes PMID: 26368265
- Novel role of TNFalpha in inducing inflammatory stress response in human microvascular endothelial cells through Akt- and P38 MAPK-mediated expression of TSP-1, independent of NFkappaB signaling. PMID: 25963668
- Plasma thrombospondin-1 concentrations are elevated obviously and are highly associated with long-term outcome of ischemic stroke PMID: 26296896
- TSP1 up regulation might be critically involved in the disease progression with rheumatoid arthritis. PMID: 25934826
- The THBS1 N700S polymorphism was associated with coronary artery disease risk. PMID: 25976449
- DLL4/Notch1 and BMP9 interdependent signaling induces endothelial cell quiescence via P27KIP1/thrombospondin pathway. PMID: 26471266
- Authors demonstrated that TSP-1 mRNA expression level was significantly upregulated in inflamed periodontitis gingival tissues PMID: 25501558
顯示更多
收起更多
-
亞細(xì)胞定位:Secreted. Cell surface. Secreted, extracellular space, extracellular matrix. Endoplasmic reticulum. Sarcoplasmic reticulum.
-
蛋白家族:Thrombospondin family
-
數(shù)據(jù)庫(kù)鏈接:
Most popular with customers
-
-
YWHAB Recombinant Monoclonal Antibody
Applications: ELISA, WB, IHC, IF, FC
Species Reactivity: Human, Mouse, Rat
-
Phospho-YAP1 (S127) Recombinant Monoclonal Antibody
Applications: ELISA, WB, IHC
Species Reactivity: Human
-
-
-
-
-